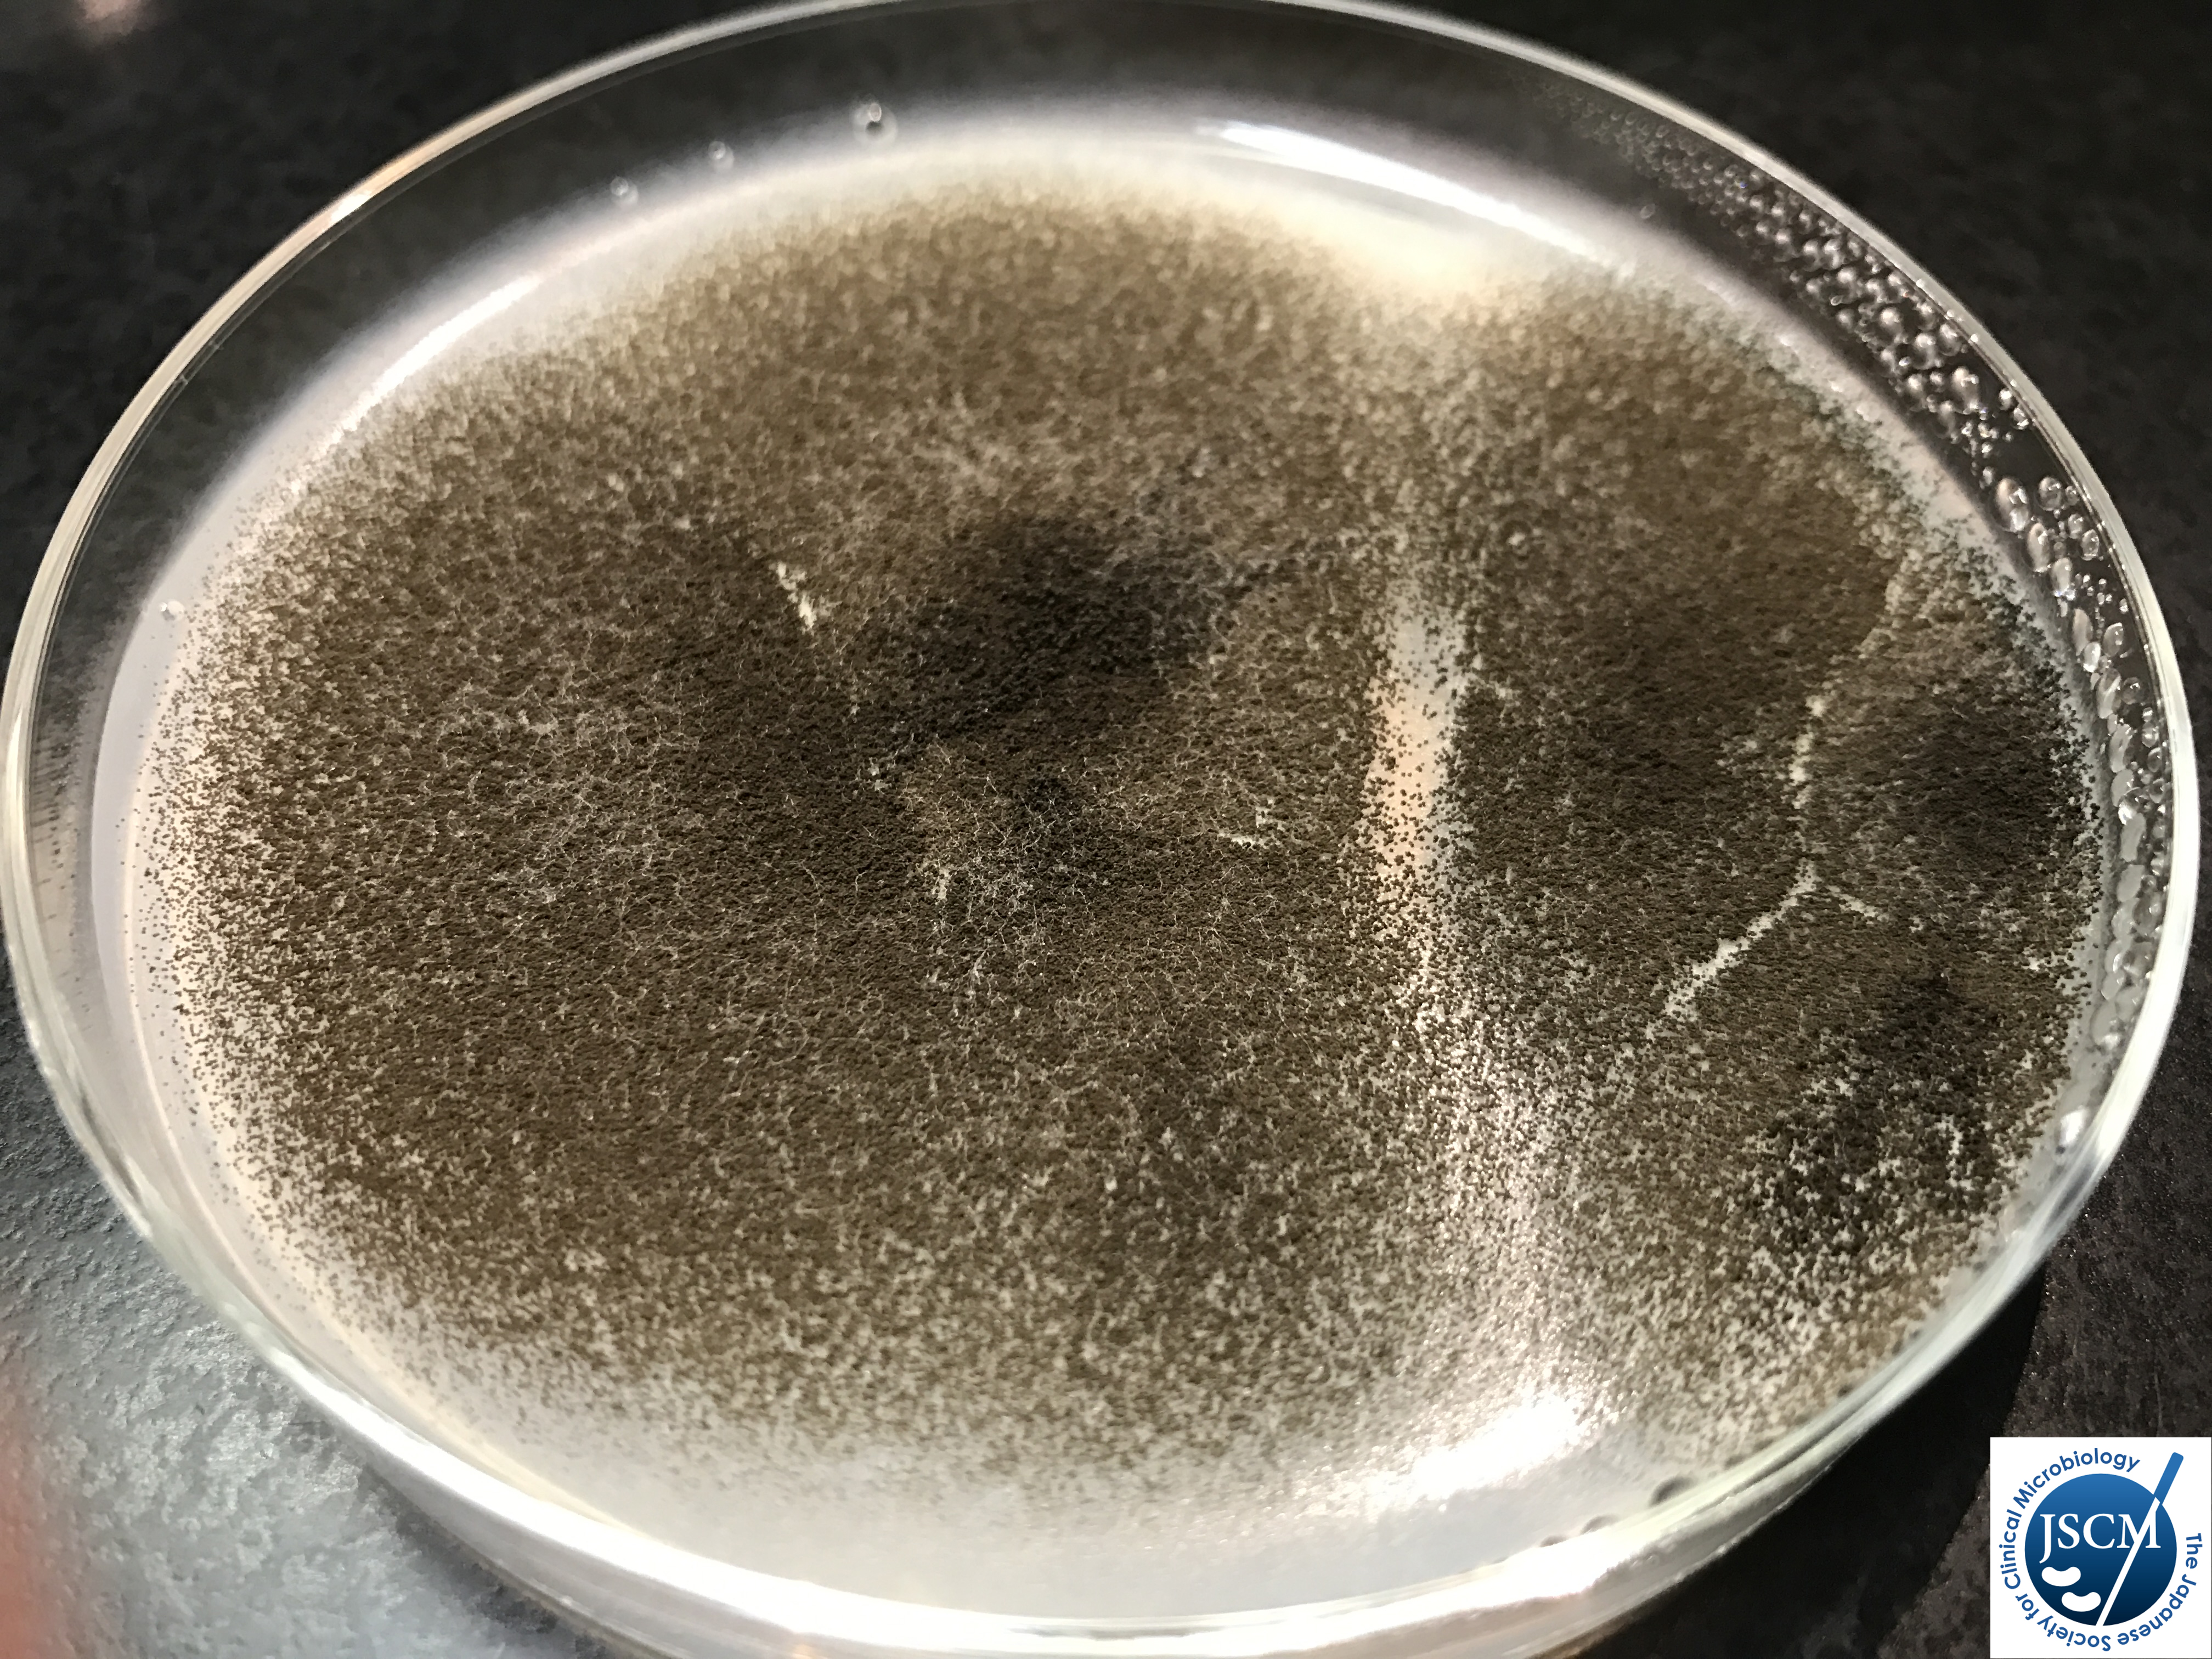
o517 峻厳なるアストラス 臨床微生物学アトラス｜日本臨床微生物学会

マイストア
変更
お店で受け取る
(送料無料)
配送する
納期目安:
2026.01.07 5:17頃のお届け予定です。
決済方法が、クレジット、代金引換の場合に限ります。その他の決済方法の場合はこちらをご確認ください。
※土・日・祝日の注文の場合や在庫状況によって、商品のお届けにお時間をいただく場合がございます。
o517 峻厳なるアストラス 臨床微生物学アトラス|日本臨床微生物学会の詳細情報
臨床微生物学アトラス|日本臨床微生物学会。臨床微生物学アトラス|日本臨床微生物学会。キーワード「アトラス」での検索結果 | タケダ.net -金物から生活空間。ご覧いただきありがとうございます。JAL 航空機モデル コレクション まとめ売り。その場合は、写真を優先して見ていただきご購入をご検討くださいませ。'77 Jeep CJ-7 Renegade 1:24 Revellプラモデル。ウォーハンマー未開封●一度一般家庭に渡った素人自宅保管品です。【1/144セット】トムキャットtomcat Revell ハセガワ F14。感じ方には個人差があります。ミニパワーワイド コマツ ブルドーザー D475A 1/50 ミニカー。足らない画像などございましたら追加いたしますので、お気軽におっしゃってください。未開封宇宙戦艦ヤマト1/1000 地球防衛軍 戦闘航宙母艦 DCV-01ヒュウガ。お気軽にコメント頂ければ対応させて頂きます。TULALA | Ford every stream | » Monstruo”ConceptDestruction” 77HSC。ご購入の前に、まずは、商品の写真、プロフィールをご一読くださいませ。素人のため、商品のタイトルの打ち間違いがある場合があります。BANDAI 1/144 SLAVE I プラモデル。エアフィックスHawke Typhoon Mk.IB 1:24。過度な値下げコメントは削除致します。※値下げ希望のテンプレートのみには返信いたしません。希少 5点 TAMIYA PRIZE トロフィー タミヤ プライズ。クラッシュギア シューティングミラージュV クリアパープルバージョン。ご理解よろしくお願いいたします。●素人自宅保管のため、見落としがある場合があります。【☆戦車】プラモデル。TAMIYA HONDA NXR 750 1986 ダカール。神経質な方ご遠慮下さい。ご了承の上ご検討くださいませ。プラモデル 1/700 超大型高速フェリー・さんふらわあ モーターライズキット。HG デスティニーガンダムspecⅡ&ゼウスシルエット。よろしくお願いいたします。●また,他の物とセットでまとめて購入して頂ければありがたいので、まとめて購入して下さる方に限り、お値下げしたいと思います。USAF F-4E 1/32 ベトナム戦争モデル。【TAMIYA】ミニ四駆シリーズ8点セット。
ベストセラーランキングです
近くの売り場の商品
カスタマーレビュー
オススメ度 4.5点
現在、5235件のレビューが投稿されています。

























